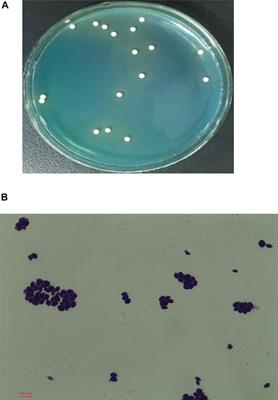

Original Research
Published on 22 Aug 2022
The potential of caproate (hexanoate) production using Clostridium kluyveri syntrophic cocultures with Clostridium acetobutylicum or Clostridium saccharolyticum
in Industrial Biotechnology
- 5,931 views
- 16 citations